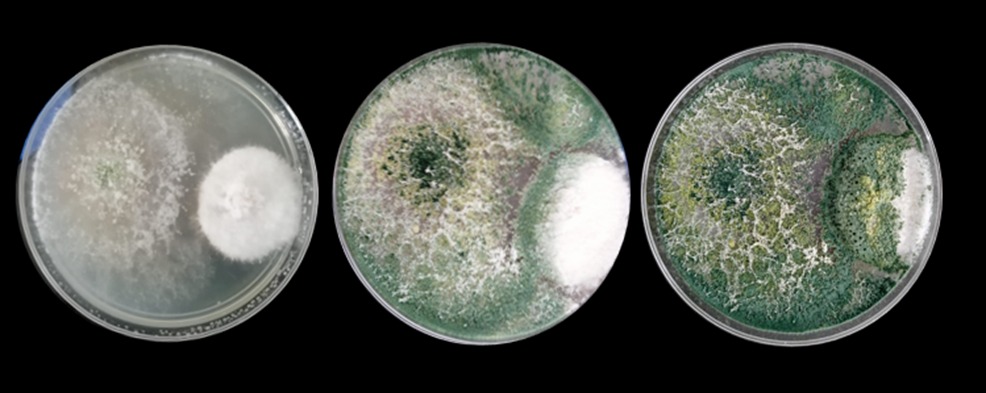
MICROORGANISMOS1

¿Quienes somos?
Somos una startup agrobiotecnológica fundada en 2022. Nuestro equipo fundador cuenta con más de 15 años de experiencia en investigación científica, impulsando la innovación para el desarrollo de soluciones sostenibles en el sector agrícola.
Nuestros fundadores

Rocío Hernández
Doctora en Ciencias por la Universidad Michoacana de San Nicolás de Hidalgo

Daniel Rojas
Doctor en Ciencias por la Universidad Michoacana de San Nicolás de Hidalgo